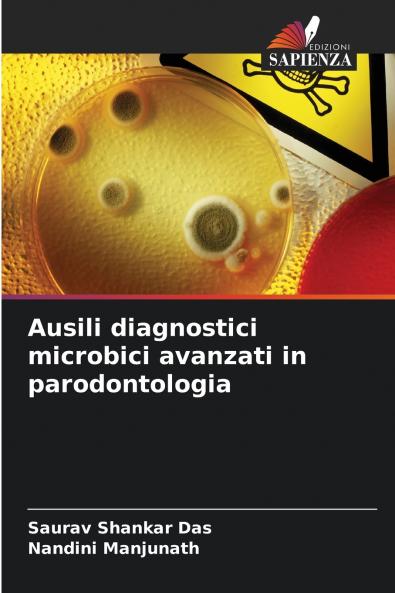
Ausili diagnostici microbici avanzati in parodontologia

Italian
Paperback
₹10224
₹13440
23.93% OFF
(All inclusive*)
Delivery Options
Please enter pincode to check delivery time.
*COD & Shipping Charges may apply on certain items.
Review final details at checkout.
Looking to place a bulk order? SUBMIT DETAILS
About The Book
Description
Author(s)
Il presente libro ha lo scopo di confrontare la capacità di diversi metodi di rilevamento ad esempio una coltura anaerobica a diluizione seriale e/o una procedura microscopica una procedura con sonda del DNA e reagenti immunologici utilizzando sia un test di immunoassorbimento enzimatico (ELISA) che un test di immunofluorescenza indiretta (IFA) per rilevare un pannello selezionato di organismi parodontopatici in campioni di placca sottogengivale singoli prelevati da siti affetti da malattia parodontale.
Delivery Options
Please enter pincode to check delivery time.
*COD & Shipping Charges may apply on certain items.
Review final details at checkout.
Details
ISBN 13
9786206826057
Publication Date
-02-05-2025
Pages
-244
Weight
-336 grams
Dimensions
-152x229x14.07 mm